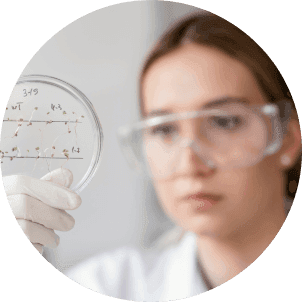
iridotest

Популярные товары
Урология
ПодробнееПаразиты
ПодробнееКрасота, молодость, здоровье
ПодробнееЖенское и мужское здоровье
ПодробнееЖКТ
ПодробнееПовышение иммунитета
ПодробнееСердце и сосуды
ПодробнееНервная система
ПодробнееПомощь в выборе препарата
Для бесплатной консультации заполните форму или свяжитесь с нами удобным способом
Комплексы
О компании
Продукция компании внесена в Федеральный справочник «Здравоохранение России» Минздрава РФ.
Узнать подробнее

Новости
Иридотест
Всего за 50 минут вы безопасно и безболезненно узнаете о своем здоровье и причинах хронических состояний. Компания Оптисалт разработала уникальную методику компьютерного тестирования, определяющую уровень паразитарной нагрузки и дефицит микроэлементов. Иридотест оценит состояние ваших органов и даст рекомендации по препаратам компании Оптисалт.

Отзывы
Все отзывыПолезные ссылки
Подпишитесь на рассылку, чтобы знать о всех акциях и новостях
Оформляя подписку, даю согласие на обработку персональных данных